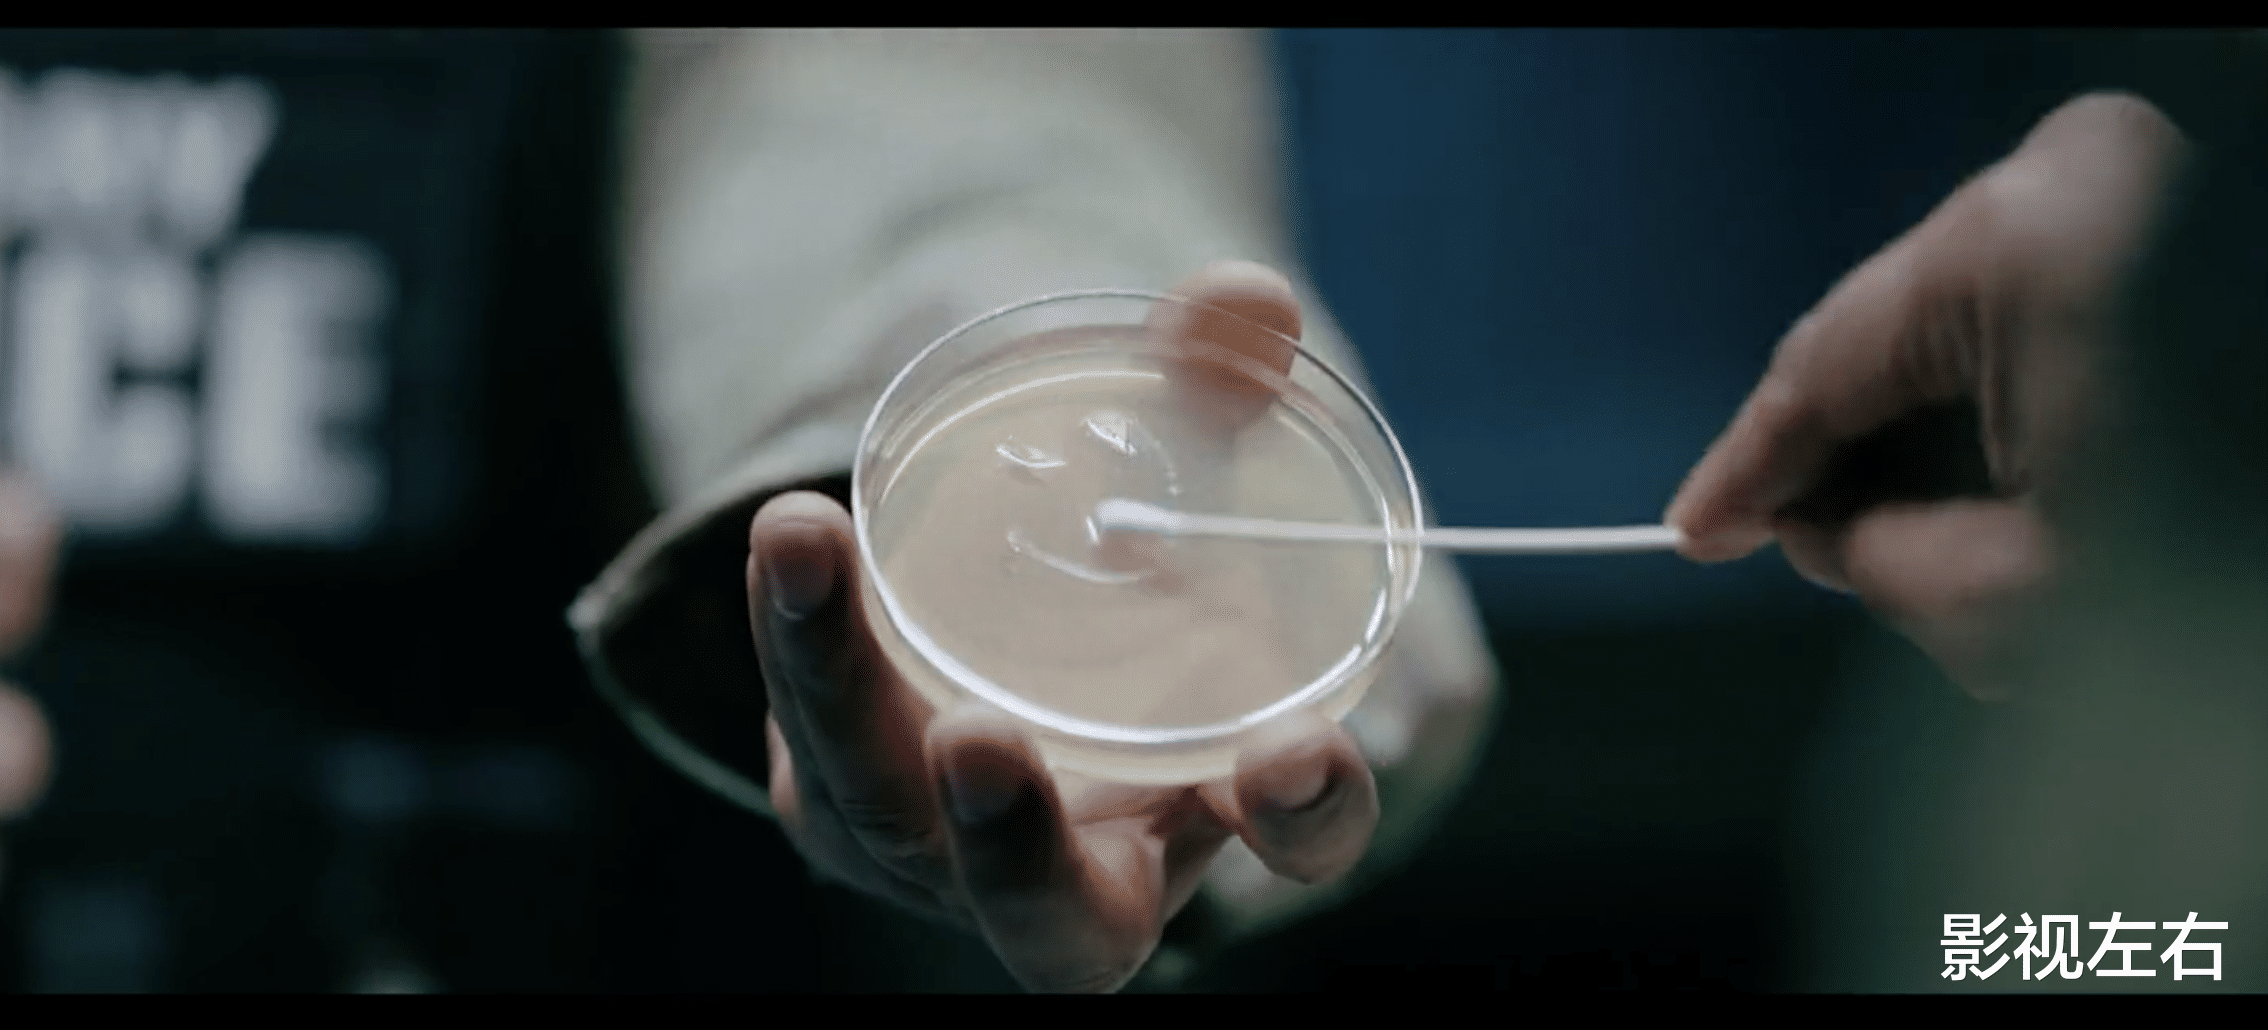

如果,全世界突然任由你支配、配合你的话,你最想做什么?会怎么做?
《同乐者》的女主选择暴怒。

因为她不想接受突如其来的巨变,不想要动机不明的讨好,所以她很生气,以至于她无意中引发了1100万人的死亡。


正在热播的科幻心理惊悚剧《同乐者》非常值得一看,它由《绝命毒师》《风骚律师》主创团队打造。
剧集讲述了600光年外携带RNA配方的外星信号,通过美国一家实验室的小白鼠感染了一个女人。


女人通过强吻的方式,将病毒通过唾液传染给她的同事。然后,他们继续以同样的方式感染了整个实验室的值班人员。

接着,所有实验室的被感染者开始协同制造含有他们唾液的培养皿,之后病毒迅速传播到了全世界。

全球人类要么被感染转换成——被病毒控制只知道快乐和一致行动的工具人,要么在感染后死亡,除了12个特例。


女主就是12个特例之一,其他11人分别分布在全球不同国家和地区。其中,中国的未感染者是一个年纪比较大的女士,印度的未感染者是一个跟女主差不多年纪的女人。


私以为,这部剧的精彩看点不在于剧情多么引人入胜,而是通过与众不同的关键元素设定,引发观众的追剧欲望与复杂观感。
首先,女主是反套路且主体性很强、有着神秘感具备多重性格矛盾的设定。
在剧中,女主卡萝尔(蕾亚·塞洪 饰演)是有自我憎恨倾向的畅销书作家。在世界被病毒感染以前,女主的人设就不是很讨喜,像一个很难被讨好的扫兴狂,什么事到她那里都会变得很丧。
不过,女主的本质并不坏,第一集中,看到路边车里有人抽搐,她会努力施救;为女友寻求急救支援的时刻,看到险些掉落的婴儿篮,也会第一时间去放稳。



其次,病毒特性的设定非常新奇有趣:人被病毒感染后,感染者之间会共享记忆、意识、资源与能力。
虽然会失去自主意识、独特性,甚至有转化期的死亡风险,但所有感染者都变得非常开心和满足,他们不说谎、不欺骗、不杀生、不贪婪……
最神奇的是,被感染后,战争、谋杀、抢劫等人类自古难以杜绝的罪恶行径悉数消失了,并且那些感染者会想尽一切办法让未感染者开心,竭力满足他们的一切要求。



再次,病毒的隐喻色彩非常丰富,每个人都可以基于自己认知有不同的理解。就像12个未感染者一样。面对同样的巨变,12个人的反应各不相同。
其中,有的人大肆利用改变来满足自己各种各样的私欲,有的人则期待变得和被感染的家人一样,女主是其中反应最强烈、最拒绝改变的。
因为女主的暴怒还引发了病毒的隐藏威胁,即未感染者暴怒会引发全世界感染者的痉挛、抽搐等转化反应,很多感染者可能会因此丧命。
最后,12个未感染者的选择和行径也从不同侧面深度探讨了人性的黑暗与不堪。剧集对人性黑暗属性的探讨与揭示,主要通过女主的行径与选择呈现。
比如,女主第一次暴怒导致1100万感染者死亡,知道这一结果的女主恶心到崩溃,但是当感染者们没有真正让她如愿的时候,她还是不管不顾地再次暴怒,尽管她已经知道她的暴怒会引发大量死亡。
再比如,她生气时自己要求感染者给她一颗手榴弹,感染者为了取悦她就给了她一颗手榴弹。她以为手榴弹是假的,便引爆了手榴弹,感染者为了救她被炸成重伤,她自己的家也被炸成废墟。结果她又怪感染者真给了她一颗手榴弹。



全剧共九集,从前四集看,会发现非常恐怖的事情:那就是一个没有战争、没有罪恶、人人平等的世界,也许并不是所有人的愿景。

因为人性黑暗、险恶的普遍性,总会有人为了一己私欲甚至一时的情绪,置千万人的生命于不顾。
正如剧集中的女主,她充其量只是一个脾气暴躁、追求自我的人,并非极端恶人,但她暴怒的时候还是会把千万人的性命抛诸脑后。